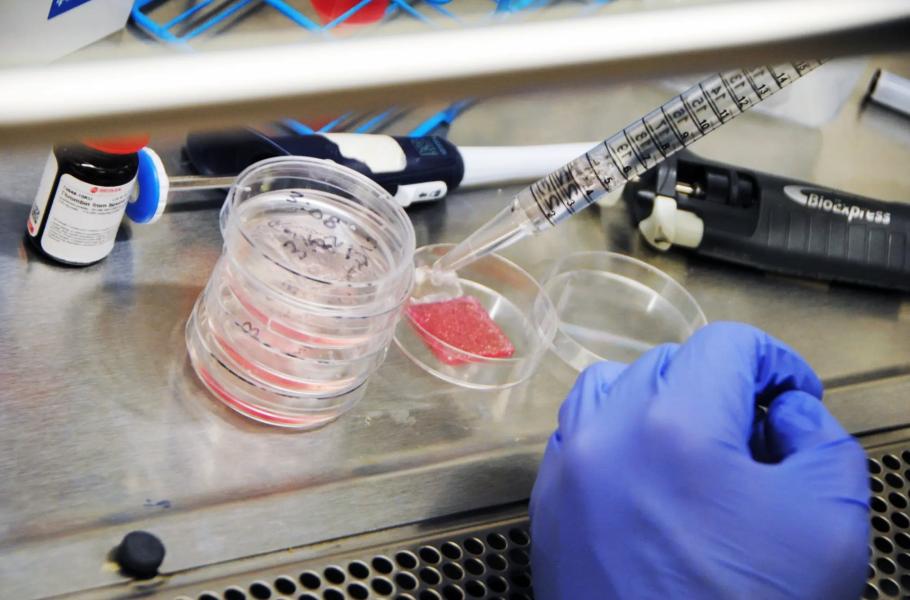

Kůže vytvořená na biotiskárně se chová a hojí téměř stejně jako ta lidská
Vědci již dovedou na biotiskárách „vytisknout“ umělou kůži obsahující živé buňky a vrstvy, které odpovídají opravdové lidské kůži. Postup by mohl najít uplatnění nejen v medicíně, ale i třeba v kosmetickém průmyslu.
Nový typ biotištěné kůže úspěšně napodobuje vrstvy a tloušťku skutečné lidské kožní tkáně. (foto: Wake Forest Institute for Regenerative Medicine, CC BY-SA 4.0)
Lidská kůže je jako první na ráně při mnoha nehodách či úrazech. Její hojení je ale bohužel leckdy komplikované, zejména v případech rozsáhlejších poškození. V posledních letech se proto objevují různé typy umělé kůže, které lze vytisknout na biotiskárnách.
Tým amerického výzkumného institutu Wake Forest Institute for Regenerative Medicine (WFIRM) učinil v tomto směru významný pokrok. Anthony Atala a jeho kolegové vyvinuli biotištěnou kůži, která obsahuje šest základních typů kožních buněk ve speciálních hydrogelech. Výsledky výzkumu Atalova týmu zveřejnil vědecký časopis Science Translational Medicine.
Kůže z tiskárny
3D biotiskárna tuto umělou kůži vytiskne ve vrstvách, které odpovídají skutečné lidské kůži. Má tenkou pokožku (epidermis) s ochrannou funkcí, pod kterou se nachází škára (dermis), čili pevná a pružná vazivová vrstva kůže. Nejhlubší vrstvu představuje podkožní vazivo (hypodermis), bohaté na tukové buňky.
Když vědci tuto novou biotištěnou kůži s vrstvami odpovídajícími skutečné kůži transplantovali myším, vytvořily se v ní krevní cévy a proběhl v ní standardní vývoj a proces hojení. Výsledkem bylo rychlejší uzavření rány a větší produkce kolagenu, což vedlo k menšímu zjizvení nově vytvořené kůže.
TIP: Ruční biotiskárna s živými buňkami usnadní léčbu těžkých popálenin
Badatelé poté celý postup zopakovali s většími kusy biotištěné kůže, tentokrát o rozměrech 5 x 5 cm, které transplantovali laboratorním prasatům. Výsledky byly velmi podobné, opět s menším zjizvením vzniklé kůže, než bývá obvyklé. Biotištěná kůže by se v budoucnu mohla uplatnit nejen u lidských pacientů, ale také při nejrůznějších kožních testech, které se dnes provádějí na živých zvířatech.



